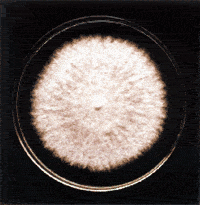

|
MICOSIS SUPERFICIALES
Muestra : Escamas de piel
Escamas de uñas
Escamas de cuero cabelludo y pelos
Método: Examen microscópico en fresco
Cultivo en medios selectivos para hongos
Significado clínico:
Las micosis superficiales incluyen las dermatoficias y la pitiriasis
versicolor.
Los dermatofitos son hongos que invaden el estrato córneo de la
piel y otros tejidos queratinizados como pelos y uñas.
Las zonas más frecuentemente afectadas son: pies, ingle, cuero
cabelludo y uñas.
Algunos dermatofitos de animales pueden transmitirse al hombre (zoofílicas)
por ejemplo Microsporum canis (perros y gatos).
Las que se transmiten a través de elementos contaminados como toallas,
sábanas, peines, cepillos, pisos de los vestuarios, almohadones
son causadas por dermatófitos antropofílicos.
Las lesiones se denominan "tiñas":
- A. Uñas: Trichophyton rubrum, Trichophyton mentagrophytes
- B. Pie: T. mentagrophytes, T. rubrum, Epidermophyton floccosum
- C. Piel del cuerpo: T rubrum, T. mentagrophytes
- D. Cuero cabelludo y pelos: Microsporum canis, M. audouinii.
- E. Tiña crural o de la ingle (tiña del gimnasio):
T. rubrum y E. floccosum.
 |
|
| Microsporum canis |
Trichophyton mentagrophytes |
La onicomicosis puede ser causada por dermatofitos y por Candida spp.
En el caso de los dermatofitos en general la lesión es distal y
lateral. Generalmente la uña se engruesa y se vuelve amarillenta.
Las más comunes se deben a T. mentagrophytes y a veces por
T. rubrum.
La infección producida por Candida spp es proximal y no
hay engrosamiento de la uña ni pérdida de brillo.
En piel puede encontrarse Malassezia spp produciendo la Pitiriasis
versicolor.
Malassezia spp produce dermatitis seborreica en el entrecejo del
recién nacido.
Toma de muestra:
- Piel : puede rasparse el borde de la zona afectada con un bisturí
y colocar el material en una caja de Petri. Otra forma es colocar sobre
la lesión una cinta adhesiva y luego colocarla sobre un portaobjetos.
En caso de intertrigo por levaduras en axilas, ingle, pliegues de dedos
o submamario tomar con hisopo la muestra.
- Uñas : la muestra se toma por raspado de la lesión
con bisturí o con algún instrumental que permita el raspado,
se coloca el mismo en una caja de Petri.
- Pelo: se raspa cuero cabelludo con un bisturí y se sacan pelos
con una pinza. Colocar el material en una caja de Petri.
Utilidad clínica:
Las muestras de uñas, pelo, piel sirven para diagnosticar una
dermatomicosis
Bibliografía:
1. María R. M. Iglesia de Elías Costa. Diagnóstico
Micológico. Curso de Microbiología Clínica. Asociación
Argentina de Microbiología. Colegio de Bioquímicos de la
Provincia de Entre Ríos. Facultad de Bioquímica y Ciencias
Biológicas. Universidad Nacional del Litoral. Módulo 6.
2. Mandel, Bennett and Dolin. Enfermedades infecciosas principios y prácticas.
Editorial Panamericana, 4°edición; Madrid, España. Año
1997.
3. Isenberg H.D., Essential procedures for clinical microbiology. 1998.
American Society for Microbiology. Library of Congress. ASM, Press.
4. Koneman Roberts. Micología. Práctica de laboratorio.
Editorial Panamericana, 3 Edición,1987.
5. Tietz N. W. Clinical Guide to Laboratory test, edited by W.B. Saunders
Company, third edition, United States of America ,1995.
|